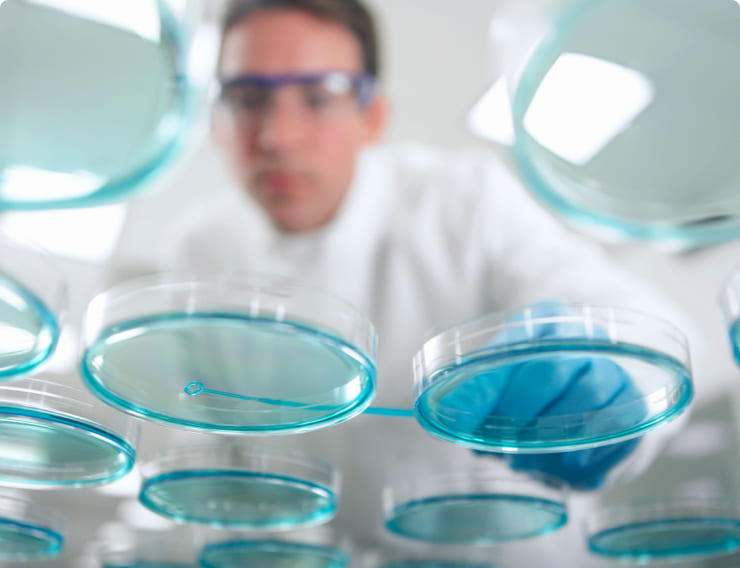
Laboratorios Farmacéuticos

LIFE & SCIENCE - HEALTHCARE
LA LOGÍSTICA PARA EL SECTOR SALUD QUE CONECTA, CUIDA, Y MEJORA LA VIDA

TU PARTNER DE LOGÍSTICA ESPECIALIZADO EN EL SECTOR SALUD
Aspectos como la seguridad, la normativa medioambiental y legislaciones gubernamentales, los exigentes protocolos de higiene en distribución y las necesidades específicas del transporte de mercancías peligrosas, pueden presentar disyuntivas en el momento de gestionar una cadena de suministro global en un entorno tan delicado como lo es el sector Salud.
Todas las empresas enmarcadas en este sector, como los centros sanitarios y hospitales, pharma retail, los laboratorios clínicos de investigación o dispositivos médicos, deben hacer frente a enormes desafíos relacionados con la evolución de la cadena de suministro, la rapidez y la calidad del servicio, así como el acceso a rutas diferenciadas en nuevos mercados.

Estas empresas juegan un papel cada vez más importante, dado el aumento de las ventas de las industrias farmacéutica y química (13.5%), el incremento del gasto público en medicamentos para hospitales (81%) y las millonarias inversiones en material sanitario, imprescindibles para hacer frente a pandemias sanitarias como la actual lucha contra el COVID-19.

La experiencia de DHL en el sector Salud, hace frente a los retos y oportunidades de la logística sanitaria y bioquímica. DHL Express España es un especialista en envíos internacionales con servicio de entrega puerta a puerta que dispone de un producto especializado, Medical Express y Medical Express Full Loop Service, hecho a medida para cubrir las necesidades de la industria farmacéutica cumpliendo con la normativa principal de Buenas Prácticas de Distribución (GDP). ¿Preparado para contar con una logística de élite?
LOGÍSTICA EN EL SECTOR SALUD
Existen importantes retos en el sector, como:
Por ello, entendemos que conseguir la mejor gestión de suministros es imprescindible en un sector que requiere rapidez y el máximo cuidado. Es más, la búsqueda de un partner logístico que garantice seguridad y calidad en cada uno de sus trayectos, resulta de vital importancia.
ESPECIALISTAS EN TRANSPORTE DE PRODUCTOS Y SOLUCIONES PARA EL SECTOR
En DHL diseñamos soluciones logísticas personalizadas para atender las necesidades que puedan surgir en tu empresa.
NUESTRAS SOLUCIONES

DHL Medical Express y Medical Express Full Loop Service
Gestionan el transporte de aquellos envíos sensibles al tiempo de tránsito y a la temperatura para la industria biomédica. Incluye el envío de sustancias biológicas o químicas, así como el envío de muestras de especímenes de los pacientes destinados a los centros de investigación.

DHL Express para el transporte de Mercancías Peligrosas
Aprobadas bajo una serie de condiciones y normativas para transporte aéreo o terrestre.
¿POR QUÉ DHL?
164
PAÍSES EN LOS QUE ESTÁ DISPONIBLE
+ 300.000
ENVIOS LIFESCIENCE & HEALTHCARE EN ESPAÑA
+ 360
QUALITY CONTROL CENTRES A NIVEL GLOBAL
DHL EN EL SECTOR LIFE SCIENCE
Cuando realizas tus envíos con DHL Express España, lo haces con el especialista en envíos internacionales y con servicio de entrega con courier. Gracias a la propia red integrada de DHL, llegamos a más de 220 países y territorios de forma rápida y fiable. Nuestra amplia gama de servicios de envío Express y paquetería y las soluciones para el seguimiento, cubren todas tus necesidades.
¡Comprueba cómo funciona DHL Express España!